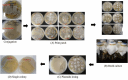
Fig. 3

Enhancing rufomycin production by CRISPR/Cas9-based genome editing and promoter engineering in Streptomyces sp. MJM3502
- PMID: 39925944
- PMCID: PMC11803874
- DOI: 10.1016/j.synbio.2025.01.002
Enhancing rufomycin production by CRISPR/Cas9-based genome editing and promoter engineering in Streptomyces sp. MJM3502
Abstract
Streptomyces sp. MJM3502 is a promising producer of rufomycins, which are a class of potent anti-tuberculosis lead compounds. Although the structure, activity, and mechanism of the main rufomycin 4/6 and its analogs have been extensively studied, a significant gap remains in our understanding of the genome sequence and biosynthetic pathway of Streptomyces sp. MJM3502, and its metabolic engineering has not yet been reported. This study established the genetic manipulation platform for the strain. Using CRISPR/Cas9-based technology to in-frame insert the strong kasO∗p promoter upstream of the rufB and rufS genes of the rufomycin BGC, we increased rufomycin 4/6 production by 4.1-fold and 2.8-fold, respectively. Furthermore, designing recombinant strains by inserting the kasO∗p promoter upstream of the biosynthetic genes encoding cytochrome P450 enzymes led to new rufomycin derivatives. These findings provide the basis for enhancing the production of valuable natural compounds in Streptomyces and offer insights into the generation of novel active natural products via synthetic biology and metabolic engineering.
Keywords: Anti-Tuberculosis; Genome mining; Promoter engineering; Rufomycin; Streptomyces sp. MJM3502.
© 2025 The Authors.
Conflict of interest statement
The authors declare the following financial interests/personal relationships which may be considered as potential competing interests: Nguyen-QuangTuan is currently employed by R&D Center, Manbangbio Co. Ltd. Jin-HuaCheng is currently employed by Microbio Healthcare Co. Ltd. Other authors declare that they have no known competing financial interests or personal relationships that could have appeared to influence the work reported in this paper.
Figures

References
-
- Bagcchi S. WHO's global tuberculosis report 2022. Lancet Microbe. 2023;4 - PubMed
-
- Dheda K., Mirzayev F., Cirillo D.M., Udwadia Z., Dooley K.E., Chang K.-C., Omar S.V., Reuter A., Perumal T., Horsburgh C.R., Jr. Multidrug-resistant tuberculosis. Nat Rev Dis Prim. 2024;10:22. - PubMed
-
- Padmapriyadarsini C., Vohra V., Bhatnagar A., Solanki R., Sridhar R., Anande L., Muthuvijaylakshmi M., Rana M.B., Jeyadeepa B., Taneja G. Bedaquiline. Delamanid, Linezolid, and Clofazimine for treatment of pre-extensively drug-resistant tuberculosis. Clin Infect Dis. 2023;76:e938–e946. - PMC - PubMed
LinkOut - more resources
Full Text Sources
Molecular Biology Databases
Miscellaneous

